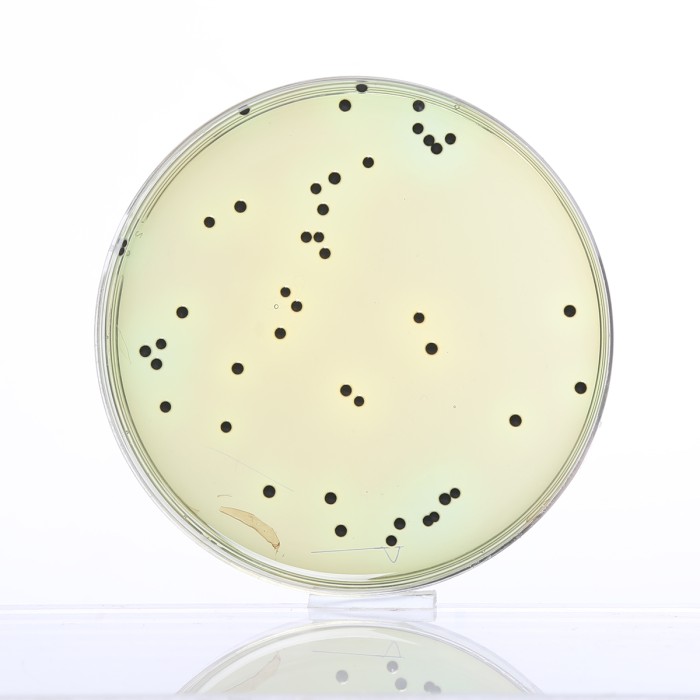
Hektoen Enteric Agar, Granulated

Your enquiry has been submitted
Hektoen Enteric Agar
Intended Use
Recommended for the isolation of Shigella and Salmonella species from enteric pathological specimens.
Composition**
| Ingredients | g/L |
|---|---|
| Proteose peptone | 12.000 |
| Yeast extract | 3.000 |
| Lactose | 12.000 |
| Sucrose | 12.000 |
| Salicin | 2.000 |
| Bile salts mixture | 9.000 |
| Sodium chloride | 5.000 |
| Sodium thiosulphate | 5.000 |
| Ferric ammonium citrate | 1.500 |
| Acid fuchsin | 0.100 |
| Bromothymol blue | 0.065 |
| Agar | 15.000 |
Final pH (at 25°C): 7.5±0.2
**Formula adjusted, standardized to suit performance parameters
Directions
Suspend 76.67 grams in 1000 ml purified/distilled water. Heat to boiling to dissolve the medium completely. DO NOTAUTOCLAVE. Cool to 45-50°C. Mix well and pour into sterile Petri plates.
Principle And Interpretation
Media that isolated a broader spectrum of enteric pathogens are less inhibitory to members of the non-pathogenic intestinal flora. Hektoen Enteric Agar was developed in 1967 by King and Metzger of the Hektoen Institute in order to increase the frequencies of isolation of Shigella and Salmonella organisms when compared with their recovery on other media frequently utilized in clinical laboratories at that time (1-3). Sodium deoxycholate has been replaced by bile salts in reduced concentration. This allows growth of Shigella as well as the Salmonellae. The peptone concentrations have been increased in order to offset the inhibitory effects of the bile salts (4). Hektoen Enteric Agar is currently recommended as one of several plating media for the culture of Enterobacteriaceae from stool specimens (5). Foods containing poultry, eggs or dairy products are the most frequent vehicles for foodborne Salmonellosis, and a variety of procedures have been developed using Hektoen Enteric Agar as part of the multi-step procedure to isolate Salmonella (6-9).
The increased concentration of carbohydrate and proteose peptone helps to reduce the inhibitory effect of bile salts and indicators and allows good growth of Salmonella and Shigella species while inhibiting the normal intestinal flora. The medium contains three carbohydrates i.e lactose, sucrose and salicin for differentiation of enteric pathogens. The higher lactose concentration aids in the visualization of enteric pathogens and minimizes the problem of delayed lactose fermentation. Salicin is fermented by many coliforms including those that do not ferment lactose and sucrose.
Combination of ferric ammonium citrate and sodium thiosulphate in the medium enables the detection of hydrogen sulfide production, thereby aiding in the differentiation process due to the formation of black centered colonies. The indicator system, consisting of acid fuchsin and bromothymol blue, has lower toxicity as compared to other enteric media, resulting in improved recovery of enteric pathogens. Hoben et al (10) further enhanced the selectivity of the medium by addition of novobiocin at a concentration of 15 mg/litre, which inhibits Citrobacter and Proteus species. Taylor and Schelhaut (11) found the medium valuable for differentiating pathogenic enteric organisms and for better growth of Shigellae.
Inoculate the medium with fresh faeces suspended in Ringers Solution or inoculate directly with rectal swabs. Spread out the inoculum to obtain isolated colonies and incubate at 35-37°C for 18-24 hours. Further incubation will improve differentiation between Salmonella and Shigella. Proteus species may resemble Salmonella or Shigella; hence further testing must be carried out for confirmation.
Type of specimen
Clinical samples : urine, faeces ; Foods, water samples
Specimen Collection and Handling
For clinical samples follow appropriate techniques for handling specimens as per established guidelines (12,13). For food and dairy samples, follow appropriate techniques for sample collection and processing as per guidelines (6,8,9).For water samples, follow appropriate techniques for sample collection, processing as per guidelines and local standards(14). After use, contaminated materials must be sterilized by autoclaving before discarding.
Warning and Precautions
In Vitro diagnostic use only. For professional use only. Read the label before opening the container. Wear protective gloves/protective clothing/eye protection/face protection. Follow good microbiological lab practices while handling specimens and culture. Standard precautions as per established guidelines should be followed while handling clinical specimens. Safety guidelines may be referred in individual safety data sheets.
Limitations
- Further incubation will improve differentiation between Salmonella and Shigella. Proteus species may resemble Salmonella or Shigella; hence further testing must be carried out for confirmation.
- Since the medium is selective it must be used in conjunction with other media.
Performance and Evaluation
Performance of the medium is expected when used as per the direction on the label within the expiry period when stored at recommended temperature.
Quality Control
Appearance
Cream to yellow with tancast homogeneous free flowing powder
Gelling
Firm, comparable with 1.5% Agar gel
Colour and Clarity of prepared medium
Green coloured, clear to slightly opalescent gel forms in Petri plates
Reaction
Reaction of 7.67% w/v aqueous solution at 25°C. pH: 7.5±0.2
pH
7.30-7.70
Cultural Response
Cultural characteristics observed after an incubation at 35-37°C for 18-24 hours.
| Organism | Inoculum (CFU) | Growth | Recovery | Colour of colony |
|---|---|---|---|---|
| Escherichia coli ATCC 25922 (00013*) | 50-100 | fair | 20-30% | orange (may have bile precipitate) |
| # Klebsiella aerogenes ATCC 13048 (00175*) | 50-100 | fair-good | 30-40% | salmon-orange |
| Enterococcus faecalis ATCC 29212 (00087*) | >=104 | inhibited | 0% | - |
| Salmonella Enteritidis ATCC 13076 (00030*) | 50-100 | luxuriant | >=50% | greenish blue may have black centres (H2S production) |
| Salmonella Typhi ATCC 6539 | 50-100 | luxuriant | >=50% | greenish blue may have black centres (H2S production) |
| Salmonella Typhimurium ATCC 14028 (00031*) | 50-100 | luxuriant | >=50% | greenish blue may have black centres (H2S production) |
| Shigella flexneri ATCC 12022 (00126*) | 50-100 | luxuriant | >=50% | greenish blue |
| Escherichia coli ATCC 8739 (00012*) | 50-100 | Fair | 20-30% | orange (may have bile precipitate) |
Key: *Corresponding WDCM numbers.
# - Formerly known as Enterobacter aerogenes
Storage and Shelf Life
Store between 10-30°C in a tightly closed container and the prepared medium at 20-30°C. Use before expiry date on the label. On opening, product should be properly stored dry, after tightly capping the bottle inorder to prevent lump formation due to the hygroscopic nature of the product. Improper storage of the product may lead to lump formation. Store in dry ventilated area protected from extremes of temperature and sources of ignition Seal the container tightly after use. Product performance is best if used within stated expiry period.
Disposal
User must ensure safe disposal by autoclaving and/or incineration of used or unusable preparations of this product. Follow established laboratory procedures in disposing of infectious materials and material that comes into contact with clinical sample must be decontaminated and disposed of in accordance with current laboratory techniques (12,13).
Reference
- King S. and Metzger W. I., 1967, Abstr. M99, p. 77. Bacteriol. Proc. Am. Soc. Microbiol.
- King S. and Metzger W. I., 1968, Appl. Microbiol., 16:577.
- King S. and Metzger W. I., 1968, Appl. Microbiol., 16:579.
- MacFaddin J. F., 1985, Media for Isolation-Cultivation-Identification-Maintenance of Medical Bacteria, Vol. I. Williams & Wilkins, Baltimore, Md.
- Murray P. R., Baron E. J., Jorgensen J. H., Pfaller M. A., Yolken R.H., (Eds.), 8th Ed., 2003, Manual 6. FDA Bacteriological Analytical Manual, 2005, 18th Ed., AOAC, Washington, DC.
- Salfinger Y., and Tortorello M.L. Fifth (Ed.), 2015, Compendium of Methods for the Microbiological Examination of Foods, 5th Ed., American Public Health Association, Washington, D.C.
- Wehr H. M. and Frank J. H., 2004, Standard Methods for the Microbiological Examination of Dairy Products, 17th Ed., APHA Inc., Washington, D.C.
- Williams, (Ed.), 2005, Official Methods of Analysis of the Association of Official Analytical Chemists, 19th Ed., AOAC, Washington, D.C
- Giannella R. A., 1996, Salmonella. In: Barons Medical Microbiology (Baron S et al, eds.), 4th Ed., Univ. of Texas Medical Branch, Hoben D.A., Ashton D.H.A. and Peterson A.C., 1973, Appl. Microbiol., 21:126.
- Taylor W.I. and Schelhaut, 1971, Appl. Microbiol., 21:32.
- Isenberg, H.D. Clinical Microbiology Procedures Handbook 2nd Edition.
- Jorgensen, J.H., Pfaller, M.A., Carroll, K.C., Funke, G., Landry, M.L., Richter, S.S and Warnock., D.W. (2015) Manual of Clinical Microbiology, 11th Edition. Vol. 1. of Clinical Microbiology, ASM, Washington, D.C.
- Lipps WC, Braun-Howland EB, Baxter TE, eds. Standard methods for the Examination of Water and Wastewater, 24th ed. Washington DC:APHA Press; 2023.
| Product Name | Hektoen Enteric Agar |
|---|---|
| SKU | M467 |
| Product Type | Regular |
| Physical Form | Powder |
| Origin | Animal |
| Packaging type | HDPE |
| References | 1.King S. and Metzger W. I., 1967, Abstr. M99, p. 7 2.King S. and Metzger W. I., 1968, Appl. Microbiol., 16:577. 3.King S. and Metzger W. I., 1968, Appl. Microbiol., 16:579. 4.MacFaddin J. F., 1985, Media for Isolation-Cultivation-Identification-Maintenance of Medical Bacteria, Vol. I. Williams &Wilkins, Baltimore, Md. 5.Murray P. R., Baron E. J., Jorgensen J. H., Pfaller M. A., Yolken R.H., (Eds.), 8th Ed., 2003, Manual of Clinical Microbiology,ASM, Washington, D.C. 6.Wehr H. M. and Frank J. H., 2004, Standard Methods for the Microbiological Examination of Dairy Products, 17th Ed.,APHA Inc., Washington, D.C. 7.FDA Bacteriological Analytical Manual, 2005, 18th Ed., AOAC, Washington, DC. 8.Williams, (Ed.), 2005, Official Methods of Analysis of the Association of Official Analytical Chemists, 19th Ed., AOAC,Washington, D.C 11.Taylor W.I. and Schelhaut, 1971, Appl. Microbiol., 21:32. 12.Isenberg, H.D. Clinical Microbiology Procedures Handb0ook. 2nd Edition. 13.Jorgensen,J.H., Pfaller , M.A., Carroll, K.C., Funke, G., Landry, M.L., Richter, S.S and Warnock., D.W. (2015)Manual of Clinical Microbiology, 11th Edition. Vol. 1. |